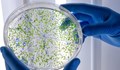
Фармацевт разясни разликите между пробиотици, синбиотици, постбиотици и парабиотици

Фармацевт разясни разликите между пробиотици, синбиотици, постбиотици и парабиотици
Харесвания: 0
Коментари: 0
Харесвания: 0
Коментари: 0
Семеен скандал.
Жената крещи:
– Господи, защо не ме прибереш?
Мъжът:
– Господ да не е луд като мене, ма...
Катастрофа с камион спря тролеите по 7 линии в Русе
Полша е прехванала два руски изтребителя над Балтийско море
Катастрофа с камион спря тролеите по 7 линии в Русе
Ивелин Михайлов: „Величие“ победи олигархията
Полша е прехванала два руски изтребителя над Балтийско море